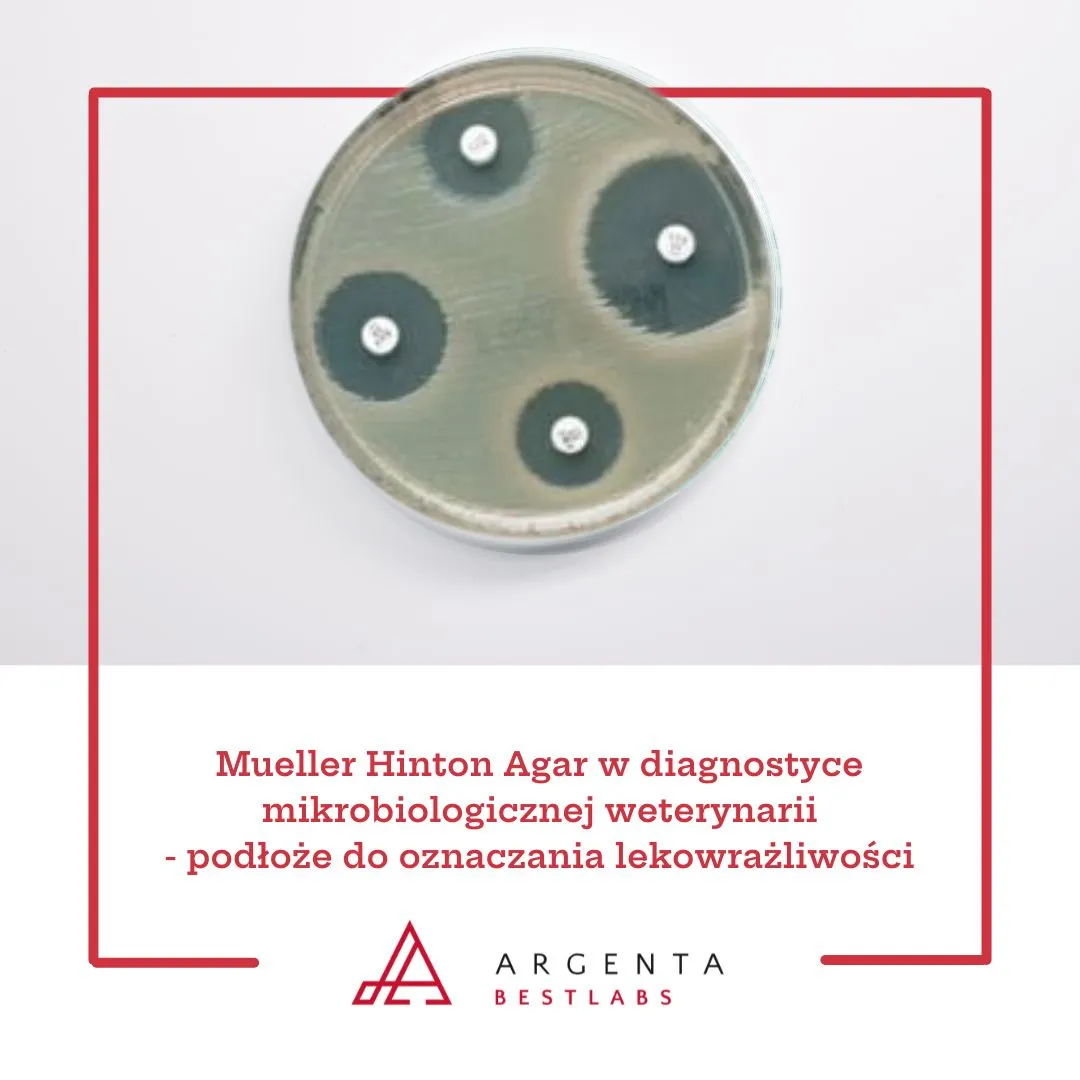
Mueller Hinton Agar w diagnostyce mikrobiologicznej weterynarii - podłoże do oznaczania lekowrażliwości

Mueller Hinton Agar to gotowa pożywka mikrobiologiczna, opracowana do precyzyjnego oznaczania lekowrażliwości drobnoustrojów. W branży weterynaryjnej odgrywa kluczową rolę w badaniach AST (Antimicrobial Susceptibility Testing), pozwalając na ocenę skuteczności antybiotyków wobec patogenów pochodzących od zwierząt gospodarskich i towarzyszących.
Znaczenie oznaczania lekowrażliwości w weterynarii
Problem antybiotykooporności u zwierząt wymaga stosowania standaryzowanych metod laboratoryjnych. Testy dyskowo-dyfuzyjne na podłożu Mueller Hinton stanowią jedną z wykorzystywanych metod w laboratoriach mikrobiologii weterynaryjnej. Dzięki nim możliwe jest m.in.:
- określenie wrażliwości patogenu na konkretne substancje przeciwdrobnoustrojowe,
- monitorowanie oporności w stadach i populacjach zwierząt.
Właściwości Mueller Hinton Agar
Produkt oferowany przez markę Oxoid to wyrób medyczny przeznaczony do profesjonalnego zastosowania laboratoryjnego. Płytki o średnicy 90 mm zawierają specjalnie opracowane podłoże Mueller Hinton, charakteryzujące się:
- odpowiednim pH i osmolalnością - zapewniającymi jednolite rozprzestrzenianie się antybiotyku,
- zawartością skrobi - wiążącej toksyczne metabolity bakterii i stabilizującej warunki wzrostu,
- zgodnością z wytycznymi CLSI i EUCAST - umożliwiającą standaryzację badań między laboratoriami.
Jak działa test lekowrażliwości na Mueller Hinton Agar?
Metoda dyfuzji krążkowej (Kirby-Bauer) na płytkach Mueller Hinton opiera się na analizie stref zahamowania wzrostu wokół umieszczonych krążków z antybiotykami:
- Na gotową płytkę nanosi się zawiesinę badanego szczepu bakteryjnego.
- Umieszcza się krążki antybiotykowe (np. gentamycyna, amoksycylina, enrofloksacyna).
- Po inkubacji odczytuje się średnice stref zahamowania - określając wrażliwość, pośrednią wrażliwość lub oporność.
Przykładowe zastosowania w weterynarii
Mueller Hinton Agar znajduje szerokie zastosowanie m.in. w laboratoriach wykonujących badania próbek od:
- psów i kotów,
- zwierząt gospodarskich,
- ptaków,
- dzikich zwierząt oraz zwierząt egzotycznych.
Zalety gotowych płytek w codziennej praktyce
- Oszczędność czasu - płytki są gotowe do użycia bez konieczności autoklawowania i dozowania.
- Powtarzalność wyników - eliminacja błędów wynikających z ręcznego przygotowywania podłoża.
- Stała jakość - każda partia produkowana według kontrolowanych procedur.
Dane techniczne
- Średnica płytki: 90 mm
- Opakowanie: 10 sztuk
- Producent: Oxoid
- Wyrób medyczny: przeznaczony wyłącznie do użytku profesjonalnego
Oferowane produkty na Bestlabs
W kategorii Gotowe podłoża hodowlane na płytkach dostępne są również m.in.:
- Mueller Hinton Agar with Sheep Blood - do oznaczania lekowrażliwości szczepów wymagających (np. Streptococcus spp.).
- Columbia Agar z krwią owczą - do izolacji i oceny hemolizy patogenów odzwierzęcych.
Mueller Hinton Agar do oznaczania lekowrażliwości
Opisywany w artykule produkt to wyrób medyczny przeznaczony wyłącznie do użytku profesjonalnego, zgodnie z art. 2 pkt 1.26 Ustawy o wyrobach medycznych. Produkt nie jest przeznaczony do stosowania w warunkach domowych. Szczegółowe informacje o przeznaczeniu, zastosowaniu oraz zasadach zakupu znajdują się na stronie produktu w sklepie bestlabs.pl.